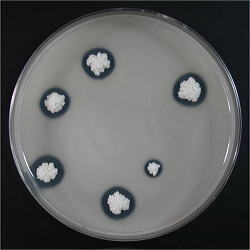

◆◇◆ ━━━━━━━━━━━━━━━━━━━━━━━━━━━ ◆◇◆
NBRCニュース No. 12(2011.12.1)
◆◇◆ ━━━━━━━━━━━━━━━━━━━━━━━━━━━ ◆◇◆
NBRCニュース第12号をお届けします。NBRCニュースも創刊からもうすぐ2年
を迎えます。編集局では皆様のお役に立つ情報を提供していきたいと考えてお
ります。以下のページで、これまでの記事や今後掲載を希望される情報などに
ついて、ご意見を募集しております(1月31日まで)。簡単なアンケートです
ので、ご協力のほどよろしくお願いいたします。
(アンケートは終了しました。ご回答いただきまして誠にありがとうございます。)
======================================================================
内容
======================================================================
1.特許微生物寄託業務一元化に関するお知らせ
2.新たにご利用可能となった微生物株(2011年10月1日~11月22日)
3.微生物あれこれ(9)
大腸菌K-12派生株とDNAリソース
4.微生物の培養法(6)
乾燥・凍結感受性酵母の復元培養、生酸性(酸生産性)酵母の培養
5.アジアの微生物(6)
モンゴル、第一印象は「とにかく広い国!」
6.カルタヘナ法-はじめての産業利用申請-(2)
研究開発利用と産業利用の違いについて
7.NITEバイオテクノロジーセンターの出展のお知らせ
======================================================================
1.特許微生物寄託業務一元化に関するお知らせ
======================================================================
この度、NITE特許微生物寄託センター(NPMD)と産業技術総合研究所特許生
物寄託センター(IPOD)は業務の効率化を図る観点から平成24年4月をもって
NITEに一元化することとなりました。
今回の一元化は昨年末に政府から示された「独立行政法人の事務・事業の見
直しの基本方針(平成22年12月7日閣議決定)」における「産業技術総合研究
所の特許生物寄託センターと製品評価技術基盤機構の特許微生物寄託センター
を統合することとし、平成23年度以降、順次、必要な措置を講ずる。」との決
定を受けたことによるものです。
詳細は以下のホームページをご覧下さい。
【詳細】 https://www.nite.go.jp/nbrc/patent/information/20111116.html
======================================================================
2.新たにご利用可能となった微生物株(2011年10月1日~11月22日)
======================================================================
糸状菌 2株、細菌 44株、アーキア 1株、微生物ゲノムDNA 1種類を新たに公
開しました。
【新規公開一覧】
https://www.nite.go.jp/nbrc/cultures/nbrc/new_strain/new_dna.html
======================================================================
3.微生物あれこれ(9)
大腸菌K-12派生株とDNAリソース (清田純也)
======================================================================
NBRCでは微生物株だけでなくDNAリソースも扱っています。ご存じでしょう
か?NBRCが保有しているヒトcDNAはプラスミドにクローニングされ、増幅・保
存等には大腸菌を利用しています。今回は、NBRCのDNAリソースを支えている
大腸菌K-12株とその派生株を取り上げたいと思います。
 大腸菌 NBRC 3301 |
大腸菌K-12株は、1922年にヒ トの糞便から分離され、Stan- ford大学で保存されていました。 K-12という番号は、Stanford大 学の管理番号のようです。保存 後、なかなか日の目を見ること のなかったK-12株ですが、1940 年代に入り、TatumによりX線に よる栄養要求性突然変異株の作 製に使われました。1946年には LederbergとTatumにより2種類 の異なる栄養要求性を持つ株を 混合すると雌雄接合という遺伝 的組換えが起こり、それぞれの 要求性を相補することが発見さ |
れました。これがその後の遺伝学の基礎となり、K-12株が実験材料として広く 利用され、様々な派生株が生まれるきっかけとなったのです。大腸菌にはバク テリオファージというウイルスが感染し、ファージDNAが大腸菌内に注入され ます。大腸菌は自身のDNAを修飾して守りながら、外部から侵入したDNAを選択 的に切断分解する制限修飾系により、生体防御を図っています。また、新規機 能を獲得するためや、外部ストレス等によりダメージを受けたDNAを修復する ため、相同組換え反応機構も持っています。これらの性質は大腸菌が生きてい くためには重要ですが、人為的に別の遺伝子を導入し、その遺伝子由来の新し い形質を付与するには、都合が悪くなります。そこで、制限修飾系や相同組換 えに関与する遺伝子を欠損した株が作られるようになりました。現在では様々 なK-12派生株が試薬メーカー等から入手可能で、各種実験系に適した大腸菌を 選んで利用できます。大腸菌にはバイオセーフティレベル(BSL)が1の株と2 の株がありますが、K-12株とその派生株はBSL1に指定された危険性の低い微生 物です。大腸菌では、K-12株の他、B株とその派生株もBSL1に指定されており、 NBRCの保存株では、K-12株はNBRC 3301、B株はNBRC 13168に該当します。 さて、NBRCでも保存や増幅に適切なK-12派生株を選んで利用していますが、 生物学上の宿命なのか、ごく稀に、保存しているDNAリソースに点変異が入っ ていたり、大腸菌由来と思われる挿入配列が見られたりする事例があります。 品質には万全を期していますが、生物の管理は一筋縄ではいかないと考えさせ られる瞬間です。 NBRCでは、ヒトcDNAクローンの他、微生物のゲノムDNA等も扱っています。 いずれも分譲前に品質確認を行い、安心してご利用いただけるよう努めていま す。これらのDNAリソースが、皆さまのご研究の一助になれば幸いです。 【ヒトcDNA】 https://www.nite.go.jp/nbrc/cultures/dna/hflcdna.html ====================================================================== 4.微生物の培養法(6) 乾燥・凍結感受性酵母の復元培養 生酸性(酸生産性)酵母の培養 (山崎敦史) ====================================================================== 凍結や乾燥に弱い(感受性のある)酵母や、酸を生産する酵母の培養には、 少しのコツが必要です。今回はその培養法についてご紹介します。 ◆ 乾燥・凍結感受性酵母の復元培養 乾燥や凍結に弱い酵母菌としては、Ambrosiozyma、Brettanomyces、 Dekkera、Geotrichum、LipomycesやYarrowia等が知られています。また、偽菌 糸や真性菌糸を作る酵母は乾燥や凍結に弱い傾向にあるようです。これらの酵 母の乾燥標品や凍結標品を復元培養する際は、固形培地と液体培地の両方を使 用します。このとき固形培地は古く乾燥しているものよりも、新しくて水滴が 残っている状態のものを使ってください。固形培地は、水分を含んではいても その表面は乾燥状態にあり、乾燥に弱い酵母はそのまま死滅してしまうためで す。また、斜面培地の下部に液体培地が少量溜まる程度加えたもので培養する と、固形培地表面の湿度が高く維持され、復元がうまくいくこともあります。 固形培地で生育が認められない時は、しばらく液体培地での培養を続けます。 液体培地で生育すると、培養器の底に菌体がたまってきます。増殖が認められ れば、その培養物の一部を固形培地に塗抹すると固形培地上でも増殖します。 ほとんどの酵母は、L-乾燥アンプルや凍結標品から1-2日程度で復元できます が、乾燥・凍結感受性の酵母は生育が遅いものが多く、復元に1週間以上かか ることもあります。例えばLipomyces属酵母のある株では、L-乾燥アンプルか らの復元に3週間かかったことがありました。NBRCから入手した菌株が復元し ない場合は、お気軽にご相談ください。 ◆ 生酸性(酸生産性)酵母の培養
炭酸Ca入り培地での培養 |
BrettanomycesやDekkera、また 一部のKloeckera, Yarrowia及び Candida等の酵母は多量の酸を生 成するため、長期間培養すると自 らの酸によって死滅することがあ ります。これらの酵母を斜面培地 等で1、2ヶ月程度生菌として維持 する場合は、最適培地に酸の中和 剤として炭酸カルシウムを1%濃度 添加した寒天培地(YM培地をベー スにしたものはNBRC104培地)を 使用します。炭酸カルシウムは培 地に完全に溶解しないため、その ままでは培地の底に沈降します。 そのため、オートクレーブした寒 天培地を60℃程度まで冷まして培 地を攪拌し、培地中に炭酸カルシ ウムを分散させてから固化させま す。 |
炭酸カルシウム入りのプレート培地で生酸性酵母を培養すると、分泌された 酸によってコロニー周辺の炭酸カルシウムが溶解します。この部分がハロー( クリアゾーン)として観察され、酵母が酸を生産していることが分かります。 なお、生酸性酵母も、他の酵母と同じ方法で凍結保存できます。方法は、NBRC ニュース第7号をご覧ください。 ====================================================================== 5.アジアの微生物(6) モンゴル、第一印象は「とにかく広い国!」 (安齋こずえ) ====================================================================== 青い空、馬頭琴の調べ、広大な草原を駆ける遊牧民・・・と聞いたらみなさ んはどの国を連想されるでしょうか。そう、あの国モンゴルです。今では横綱 の出身国として有名ですが、風土や民族についてはご存じない方も多いかもし れません。気候は、湿度が低く乾燥しており、夏と冬、昼と夜の温度差が大き い大陸性気候です。高緯度に位置し、平均標高も約1500メートルと高いために 冬は酷寒です。しかし夏の日中には30℃を超える日も少なくありません。西部 にアルタイ山脈、南部に広大なゴビ砂漠を持ち、北部にはタイガが広がってい ます。人口は約280万人で、いくつかの民族で構成されています。首都ウラン バートルには人口の約半数が暮らしています。モンゴルの食卓では乳製品とウ ォッカと肉類がこよなく愛されています。特に乳製品はどのスーパーマーケッ トに行っても品揃えが豊富で、さすが遊牧民族の国と驚かされました。また、 スーテーツァイというモンゴルの伝統的なミルクティーが日常的に飲まれてい るのですが、こちらはなんと塩味なのです。未体験の味にびっくりしてしまい ました。 私たちはモンゴル科学院との共同プロジェクトを2006年から展開しておりま す。このプロジェクトでは現在までに約3200株の微生物をモンゴル国内から分 離・保存し、スクリーニング株という名称で皆様にご利用いただけるようにな っています。そのモンゴル株の新しい仲間を探すため、今夏も渡航してきまし た。今回の渡航ではモンゴル科学院の研究者とともに、土壌と地衣類から放線 菌の、乳製品から乳酸菌の分離を試みました。放線菌分離のサンプリングに選 んだ場所はモンゴル北西部のフブスグル湖畔。このフブスグル湖はモンゴルで 2番目に大きい淡水湖です。湖周辺一帯はステップからタイガへの移行帯で国 立公園に指定されており、素晴らしい景観を誇っています。鬱蒼としたタイガ の森の中に生きている地衣は多くの種類があり、色とりどりで形も様々。どれ もとても美しく目に映りました。乳酸菌分離のサンプリングでは、ウランバー トルからほど近いテレルジという地域で、アイラグ(馬乳酒)、タラグ(ヨー グルト)、ウルム(バタークリーム)などを収集しました。その後、モンゴル 科学院にてこれらのサンプルから目的の微生物を分離し、合わせて512株を日 本に移転しました。現在はNITEにて16S rRNA遺伝子配列の系統解析を行ってお ります。はるばる日本にやってきた512株の仲間達は果たしてどのような顔を 見せてくれるのでしょうか。あの美しい森に住んでいた菌、美味なるタラグに 一役買っていたかもしれない菌、その素顔は? 近い将来に皆様にご利用いただけるようになりますので、どうぞご期待くだ さい。 【スクリーニング株】 https://www.nite.go.jp/nbrc/cultures/rd/index.html

タイガの森 ====================================================================== 6.カルタヘナ法-はじめての産業利用申請-(2) 研究開発利用と産業利用の違いについて (深井理恵子) ====================================================================== NITEではカルタヘナ法の第二種使用(いわゆる閉鎖系)に関する問い合わせ をメールや電話などで受けていますが、今回はその中で質問が多い「組換え体 の研究開発利用と産業利用の違い」について取り上げます。 前回もお話ししたとおり、両者の間では規制の内容や手続きに違いがありま すが、そもそも管理する省も異なります。研究開発利用は文部科学省が担当し ており、研究開発時に組換え体を使用する際に守るべき内容を「研究開発二種 省令*」として定めています。一方、産業利用については関係する5つの省( 財務・厚生労働・農林水産・経済産業・環境)により「産業利用二種省令*」 を定めていますので、はじめて産業利用を検討する場合は、必ずこちらの省令 に目を通してください。 ところで、研究開発から産業利用への移行にあたって、どの段階から産業利 用とみなすのか悩む方もおられるかと思います。これについては判断が難しい のですが、産業利用二種省令では「商業化・実用化に向けた使用等を含む」と ありますので、産業利用に向けた検討が始まった段階で、申請の必要性につい ても考慮した方がよいと言えます。実際に申請が必要か否かについては、事業 内容や状態によってケースバイケースの判断となりますので、事業を担当する 省によく相談をすることが必要です。特に、「組換え体を無償で提供する場合 は産業利用ではない」と誤解されている方もおられますが、産業利用か否かは 対価の有無と関係はありませんので、ご注意ください。 次に、産業利用の管理が5省に分かれておりますので、申請しようとしてい る事業の分野がどの省の担当であるかを確認する必要があります。特にNITEに 相談が多いのは「医薬品の原料はどちらの担当か」という質問です。基本的に は、医薬品は厚生労働省、医薬品中間体の製造事業は経済産業省で対応してい ますが、判断に迷う場合は各省に相談する方が安心でしょう。なお、申請書の 提出の仕方は各省で異なりますので、それぞれの窓口やホームページなどでよ く確認してください。経済産業省への提出方法については、次号で詳しくご説 明します。 最後に一つ述べておきたいのは、研究開発の場合、病原性が高いなどの理由 により文部科学省への申請が必要なものを除き、大部分の組換え実験が機関内 での承認により実施が可能であるのに対し、産業利用においては、特別な例を 除き、ほとんどの案件が大臣確認申請を必要とするという点です。つまり、産 業利用の場合は基本的に「申請ありき」で考えていた方がよいと言えます。な お申請を必要としない事例(GILSP遺伝子組換え微生物のこと)については、 今後の連載で説明したいと思います。 *「研究開発二種省令」と「産業利用二種省令」は、バイオセーフティクリア リングハウスのホームページ(http://www.biodic.go.jp/bch/)で確認できま す。 ====================================================================== 7.NITEバイオテクノロジーセンターの出展のお知らせ ====================================================================== 以下の展示会に出展いたします。是非お立ち寄り下さい。 日本分子生物学会 特別企画「ナショナルバイオリソースプロジェクト(NBRP)」 実物つきパネル展示「バイオリソース勢ぞろい」 日程:2011年12月13日(火)~16日(金) 場所:パシフィコ横浜 http://www.aeplan.co.jp/mbsj2011/program/nbrp.html ====================================================================== 編集後記 ====================================================================== この前まで暑かったはずですが、あっという間に肌寒くなり、慌てて押し入 れからフリースやセーターを出したところです。この冬も夏と同様、節電の必 要があるそうです。節電のため、健康のためにも、週末は部屋で過ごすのでは なく、地域のイベントに参加したり、近くの公園を散歩したりしてみたいと思 います。(HS) ◆◇◆ ━━━━━━━━━━━━━━━━━━━━━━━━━━━ ◆◇◆ ・NBRCニュースは配信登録いただいたメールアドレスにお送りしております。 万が一間違えて配信されておりましたら、お手数ですが、下記のアドレスに ご連絡ください。 ・ご質問、転載のご要望など、NBRCニュースについてのお問い合わせは、下記 のアドレスにご連絡ください。 ・掲載内容は予告なく変更することがございます。掲載内容を許可なく複製・ 転載されることを禁止します。 ・偶数月の1日(休日の場合はその翌日)が発行日です。第13号は2月1日に配 信予定です。 編集・発行 独立行政法人製品評価技術基盤機構(NITE)バイオテクノロジーセンター NBRCニュース編集局(nbrcnews@nite.go.jp) ◆◇◆ ━━━━━━━━━━━━━━━━━━━━━━━━━━━ ◆◇◆








